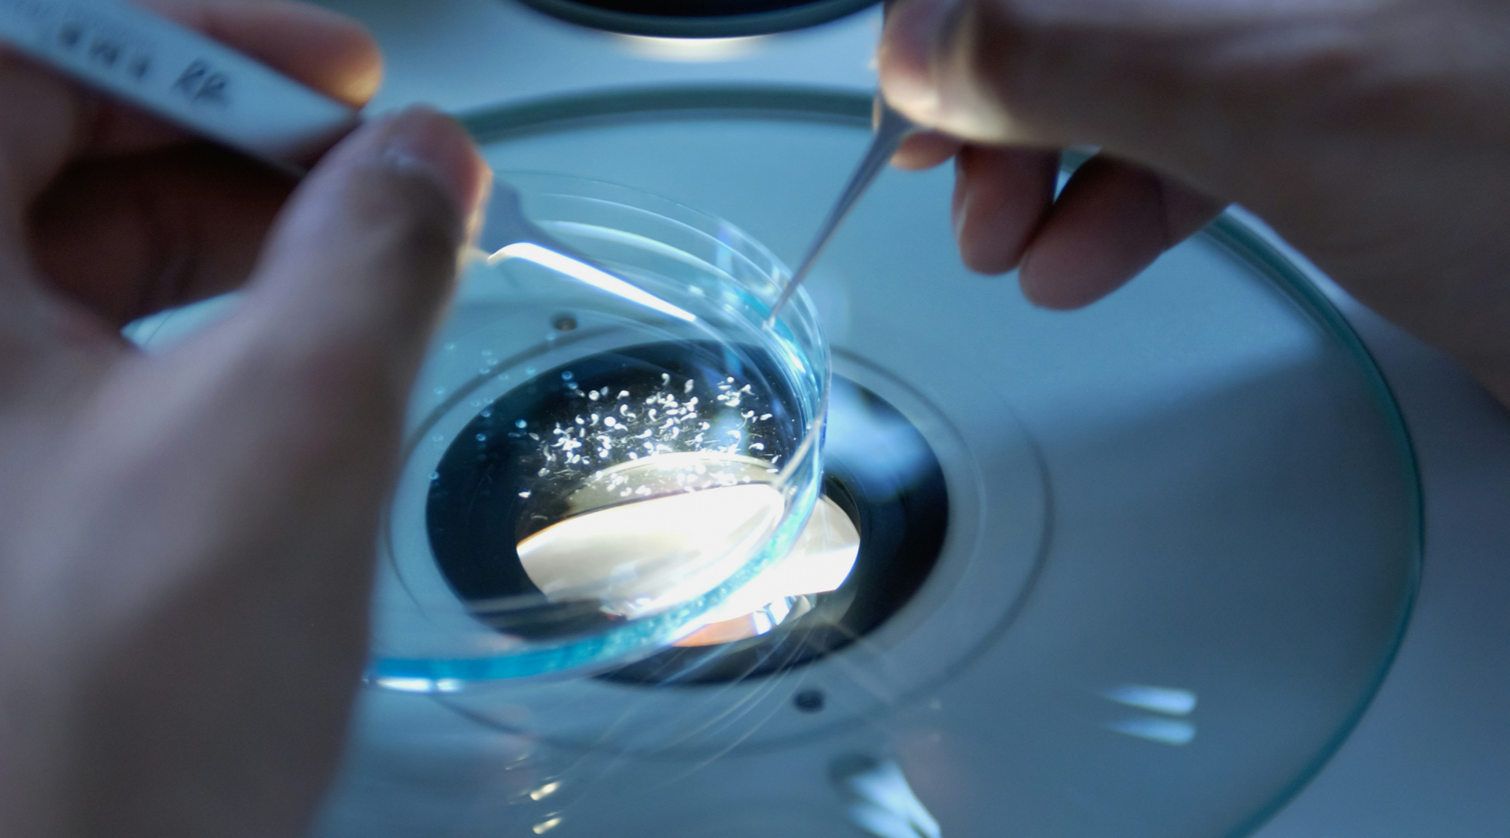

在圣希澳医学,我们坚信
科技创新是推动医疗进步的不竭动力。
我们致力于打造一个开放包容、充满活力的研发平台,
集结各领域的杰出人才,共同探索生物医药的无限潜力。
加入圣希澳医学,
我们如同阳光一般,为每一位怀揣梦想的逐梦者提供沃土,让创意和灵感在这里生根发芽、茁壮成长。我们如同向日葵一般,始终向着科学的光芒不断探索,以坚定的信念和不懈的努力,为人类健康事业绽放绚丽之花。加入圣希澳医学,让我们携手并进,用智慧和汗水谱写医疗创新的崭新篇章。在这片热情洋溢的沃土上,定能收获梦想开花结果的惊喜与感动。

圣希澳医学科技有限公司,不仅是一个追求卓越的科研平台,更是一个充满温暖与关怀的大家庭。在这里,我们一起工作,一起欢笑,一起成长。加入我们,你不仅能实现自己的职业梦想,更能收获一段难忘的人生旅程。让我们携手并肩,共创美好未来!
在这个特别的日子里,圣希澳医学中心向所有护士同仁致以最崇高的敬意和最诚挚的祝福。你们是医疗战线上最美丽的天使,用无私奉献和专业护理,为患者带去健康与希望的曙光。你们的每一次付出,都在谱写着医疗事业的华美篇章。感谢你们用爱心和汗水筑起生命的防线...

在圣希澳医学,我们有幸聚集了一批生物医学界的精英翘楚。他们凭借卓越的专业素养和深厚的科研阅历,悉心指导每一位员工的成长。通过定期举办的员工培训活动,这些行业大咖们将与您面对面,深入剖析前沿科研领域,传授宝贵的实践经验。他们以高屋建瓴的视角和鞭辟入里的讲解,为您开启通往学术巅峰的道路。
专家接触
专业技能
前沿视野
职业发展
我们视员工的成长为公司发展的核心动力。借助大咖导师的智慧引领,您将在专业领域中突飞猛进,为个人事业书写辉煌篇章。同时,您的进步也将为公司发展注入源源不断的创新活力,推动圣希澳医学在生物医药领域不断迈向新高度!
在圣希澳医学,让我们携手并肩,共同开启通往卓越的征程。这里有顶尖的平台、优秀的导师、广阔的舞台,一切只待有梦想、肯拼搏的您来绽放光彩!立即加入我们,让圣希澳医学成为您实现职业梦想的起点,成就非凡人生的摇篮!
在圣希澳医学,让我们携手并肩,共同开启通往卓越的征程。成就非凡人生!
开放、包容、充满活力的工作环境 让你每天心情愉悦
持续学习与成长的机会专业团队指导助你快速提升
富有竞争力的薪酬福利, 全面保障你的生活品质